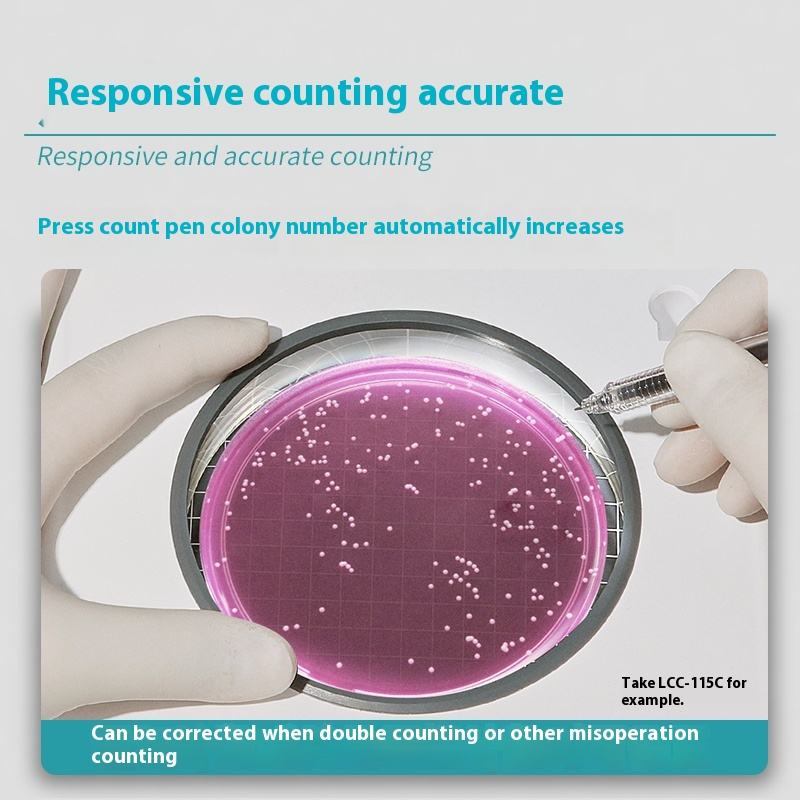

Thuộc tính
Guangdong, ChinaNơi xuất xứ
BKMAMNhãn hiệu
1000mlcông suất
ODMTùy Chỉnh Hỗ Trợ
Nhựatài liệu
1Kích thước
Bảo hành:1 năm
bán Đơn Vị:Một món hàng
độc gói kích thước:30X30X35 cm
duy nhất tổng trọng lượng:4.000 kg

Mọi khoản thanh toán bạn thực hiện trên Alibaba.com đều được bảo mật bằng mã hóa SSL nghiêm ngặt và giao thức bảo vệ dữ liệu PCI DSS

Thực hiện hoàn trả nội địa miễn phí đối với các lỗi trên các khoản mua hàng đủ điều kiện

Yêu cầu hoàn tiền nếu đơn hàng của bạn không được vận chuyển, bị thiếu hoặc sản phẩm có vấn đề khi về tay bạn

Truy cập trung tâm trợ giúp trực tuyến 24/7 của chúng tôi hoặc kết nối với nhân viên hỗ trợ trực tiếp để được trợ giúp

Quyền riêng tư về dữ liệu của bạn sẽ được bảo vệ trên toàn bộ nền tảng Alibaba.com với các biện pháp bảo mật tích hợp sẵn